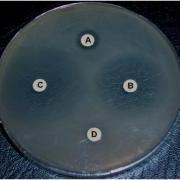

Pirosequenziamento La rilevazione del nucleotide che viene incorporato si manifesta attraverso il rilascio di pirofosfato. Fatto dall’università di Stoccolma nel 1996. Estremamente rapido, elevatissima accuratezza e riproducibilità (99%), permette il real time sequencing con risultati che dalla processazione del campione al risultato finale ci vogliono solo 2 ore. Tecnica partita con lo studio degli sNIP […]
Archivio Categoria: Biotecnologie Microbiche
È una disciplina che si propone di esplorare le potenzialità dell’utilizzo di microrganismi per diverse applicazioni biotecnologiche.
Tratta i diversi approcci metodologici mirati alla selezione ed al miglioramento genetico delle colture industriali, prende in considerazione esempi di produzione, caratterizzazione ed impiego dei principali prodotti delle fermentazioni industriali.
E’ il metodo utilizzato in laboratorio per valutare la suscettibilità di un microrganismo nei confronti di un pannello di farmaci antibiotici o antifungini a seconda del microrganismo del quale si fa la diagnosi.
Che cos’è il metodo di Sanger Questo metodo coinvolge la sintesi di nuovi filamenti di DNA complementari ad uno stampo a singolo filamento. Nel sequenziamento a terminazione di catena la reazione, oltre ad uno stampo a singola elica, ha bisogno di: un innesco specifico (primer); la marcatura con un desossinucleotide-trifosfato marcato di solito con 32S; una […]
Il vaccino è un preparato biologico contenente materiale costituito da proteine complesse a DNA, provenienti da microrganismi, trattato per non perdere le proprietà antigeniche nato per dare immunità. L’immunità deriva dalla stimolazione del sistema immunitario che stimolerà la produzione di anticorpi neutralizzanti il microrganismo stesso nel momento in cui avrà contatto con il nostro corpo. Le […]
Per malattie trasmesse dagli alimenti si intendono tutte quelle patologie che possono essere legate alla presenza di un contaminante sia di natura chimica, ma anche di natura fisica, oltre che biologica, a livello dell’alimento. Nella maggior parte dei casi il rischio legato agli alimenti è più la conseguenza di una contaminazione di tipo chimico o […]
Sono vaccini che hanno rappresentato una grossa svolta. Riuscire geneticamente ad individuare la parte antigenicamente attiva ed essere in grado di produrla, dal punto di vista sia biotecnologico, sia dell’efficacia dell’intervento vaccinale, ci da delle garanzie enormi; quindi da quando è stata disponibile la tecnologia del DNA ricombinante,se è possibile c’è la tendenza ad utilizzarla […]
Un altro aspetto rilevante nelle biotecnologie che lavora molto sull’efficacia nella pratica, è la possibilità di combinare, non bisogna confondere un vaccino coniugato in cui la parte antigenicamente attiva è coniugata in genere con un adiuvante che ne esalta la immunogenicità, a differenza dei vaccini combinati che sono preparazioni vaccinali all’interno delle quali mettiamo più […]
Un virus è una minuscola entità avvolta in una proteina, uno strato proteico che ricopre il file del DNA (genoma). entità molto elementare e semplice con le caratteristiche di parassita obbligato, in quanto si replica all'interno delle cellule viventi. I virus possono infettare tutti i tipi di forme di vita. Una volta all’interno di una […]
Il virus Zika (ZIKV) è un virus a RNA della famiglia Flaviviridae,specie Zika, isolato per la prima volta nel 1947. Partito dall’Uganda oggi diffuso in buona parte dell’Europa e non solo, anche prensente in zome come Tanzania, Egitto, Sierra Leone, Senegal e il Gabon, ma anche alcuni casi si sono riscontrati in Asia. Negli esseri […]
Le interazioni con l’ambiente sono essenziali per la sopravvivenza degli organismi viventi ma possono anche costituire una minaccia per la loro indennità e salute. Oltre che venire a contatto con microrganismi del tipo cui si è accennato, l’organismo umano può essere aggredito da virus, parassiti e sostanze tossiche di varia natura. cercheremo di descrivere i […]